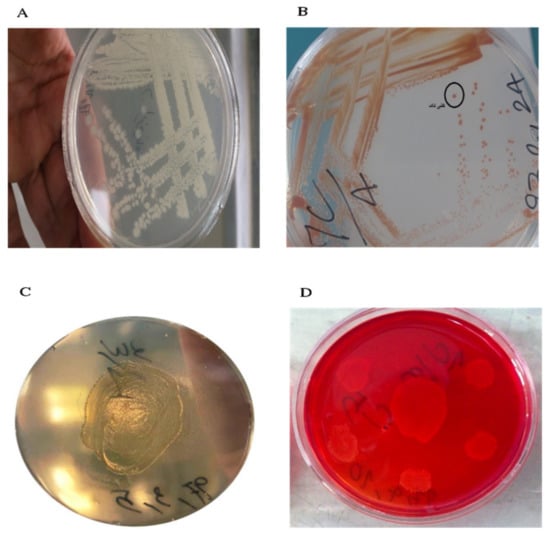

Abstract
The marine ecosystem is one of the richest sources of biologically active compounds, such as enzymes, among which seaweed is one of the most diverse marine species and has a rich diversity of bacteria that produce different enzymes. Among these, the bacteria-derived xylanase enzyme has many applications in the fruit juice, paper, and baking industries; so, to consider the economic value of the xylanase enzyme and the isolation and identification of xylanase-producing bacteria is of particular importance. In this study, specimens of the alga Ulva flexuosa species were collected from the coasts of Bandar Abbas and Qeshm Island. The bacteria coexisting with the algae were isolated using a nutrient agar medium. The bacteria producing the xylanase enzyme were then screened by a specific solid culture medium containing xylan, and the activity of the xylanase enzyme isolated from the bacteria was measured using a xylan substrate. The bacteria with the highest enzymatic activity were selected and identified by 16S rRNA gene sequence analysis, and the culture medium conditions for the enzyme production by the selected bacterial strains were optimized. Among the bacterial community, two strains with the highest xylanase activity, which belonged to the genera Bacillus and Shewanella, were identified as Bacillus subtilis strain HR05 and Shewanella algae strain HR06, respectively. The two selected bacteria were registered in the NCBI gene database. The results demonstrated that the two selected strains had different optimal growing conditions in terms of pH and temperature, as well as the sources of carbon and nitrogen for enzyme production. It seems that the xylanase enzyme isolated from the bacterial strains HR05 and HR06, which coexist with alga Ulva flexousa, could be potential candidates for biotechnology and various industries, such as pulp production, paper, and food manufacture, due to their high activity and optimal alkaline pH.
1. Introduction
Nowadays, the sea is considered one of the richest sources of new and diverse metabolites, among which seaweed is one of the most diverse marine species, and in comparison to other marine multicellular organisms, it has a wide variety of microorganisms, such as bacteria [,]. Seaweeds are one of the largest and most diverse species in the sea and play a vital role in the marine environment. They are broadly used in the food industry andglobal primary production, and they could act as a shelter for a variety of organisms. Algae also provide a protected and nutrient-rich surface for bacteria to grow []. Similarly to other multicellular organisms, algae possess a variety of dependent microorganisms, such as bacteria, which could be beneficial to them. These bacteria obtain the nutrients they need, such as vitamins, polysaccharides, and fatty acids, from their host plants or animals. Bacteria generate their own products, such as amino acids, enzymes, antibiotics, and toxins, which are suitable for the growth and metabolism of the host and the development of its chemical defense ability [,].
Xylan is a polysaccharide molecule present in the cell walls of plants and algae. Xylanase is an enzyme responsible for hydrolyzing thexylan molecules []. It has been shown that the cell walls of green seaweeds have high xylan contents. Seaweed-dependent bacteria in a xylan-rich environment have the ability to produce a variety of new metabolitesand/or enzymes, including the xylanase enzyme [,]. The xylanase enzyme is capable of hydrolyzing the β-1,4 bonds in xylan abundantly found in hemicellulose. Auxiliary enzymes play a catalytic role depending on the nature of the side chains attached to the xylan, and the cleavage of these side chains by auxiliary enzymes can help the xylan to completely break down to its monomer and produce xylose sugar [,].
The xylanase is employedfor bleaching pulp as it is cost-effective, and its use does not harm the environment. Moreover, the application of this enzyme in the fruit juice industry yields higher quality products. This enzyme is also beneficial in the bakery industry as the use of xylanase improves the texture of bread, especially in the presence of a large amount of dough. In addition, animal feed additives containing xylanase may have higher nutritional value and reduce feed costs. It is suggested that xylanase is able to contribute to producing green energy through the conversion of biomass into biodiesel and bioethanol [,]. The exploitation of the marine environment for the isolation of microorganisms with xylanase activity has superiority over land-based screening efforts. A variety of methods have been employed for screening marine microorganisms with xylanase activity. These methods are capable of distinguishing between marine xylanase and its terrestrial counterparts in terms of tolerating relatively high temperatures and pH values, as well as high salt concentrations. These properties are able to lower the probability of microbial contamination in the culture medium, provide the establishment of processes with lower upstream needs as a result of resistance to inhibitory titers of metal ions for land-extracted xylanase, and minimize the possible occurrence of unfavorable hydrolysis (e.g., in the paper and pulp industry), which results from the high selectivity of the marine-derived xylanase [,].
The isolation of xylanase-producing bacteria from Persian Gulf algae has not been reported so far. Therefore, for the first time, we aimed to extract a new xylanase-producing bacterium from a green alga Ulva flexousa in the Persian Gulf. Due to the abundance of thegreen algae Ulva flexousa in the Persian Gulf and the lack of any studies conducted on xylanase-producing bacteria from this area, the present research is not only innovative but essential. On the other hand, it will increase the scope of the science related to xylanase enzymes, which possess numerous commercial and industrial values.
2. Materials and Methods
2.1. Materials
All reagents were purchased from the Merck Company (Darmstadt, Germany).
2.2. Collection of the Green Alga Ulva Flexuosa
The specimens of the green alga Ulva flexuosa were collected from different tidal regions of the coasts of Hormozgan province, Iran, including the coasts of Bandar Abbas (27 degrees and 18 min north and 56 degrees and 32 min east) and Qeshm Island (26 degrees and 58 min north and 56 degrees and 5 min east). Algal samples were gathered in sterile containers (containing sterile seawater) at a temperature of 4–10 °C and immediately transferred to the laboratory. The sampling process was performed in three different stages and days.
2.3. Isolation of Bacteria from the Green Alga Ulva Flexuosa
In order to isolate the sand particles from the collected algal samples, they were washed with sterile seawater in two steps. The algal specimens were then completely crushed in a sterile mortar, and the resulting extract was cultured on the nutrient agar medium and incubated for 30 h at 30 °C.
2.4. Primary Screening of Xylanase-Producing Bacteria
Bacteria isolated from alga Ulva flexuosa were cultured on a specific culture medium containing xylan (5 g peptone, 20 g agar, 5 g sodium chloride, 0.5 g magnesium sulfate, 0.15 g calcium chloride, 10 g xylan, and 500 mL distilled water) and incubated at 30 °C for 48 h. At the end of the incubation period, all the colonies grown in the specific culture medium containing xylanase were tested using the Congo red test. The Congo red solution at a concentration of 0.1 mg/mL was poured on the culture medium to cover the entire surface of the plate at room temperature. After 15 min, the surface of the culture medium was washed with 1 M sodium chloride solution. The bacterial strains that produce the xylanase enzyme were isolated and selected for further research.
2.5. Secondary Screening of Xylanase-Producing Bacteria and Measurement of Enzyme Activity
Xylanase-producing bacterial strains generating a stronger halo at the initial screening stage were selected for secondary screening and enzyme activity assay. At this stage, the bacteria were cultured in a broth culture medium containing leaf mineral salts (Berg’s mineral salts agar) and incubated in an incubator shaker at 30 °C at 150 rpm. After incubation, the culture medium was centrifuged at 12,000 rpm for 20 min, and the supernatant was used as an enzyme-containing solution in the later stages of the experiment [,].
Then, 1 mL of 1% xylan as substrate with 0.5 mL of the enzyme-containing solution was mixed and placed in a vial for 50 min at 50 °C. Afterwards, 0.5 mL of the above solution (enzyme–substrate) was mixed with 1 mL of DNS (3,5-Dinitrosalicylic acid) and placed at 90 °C in a water bath for 10 min. Finally, the optical absorption of the samples was read at a wavelength of 540 nm by spectrophotometry [,].
2.6. Identification of Potential Bacteria Producing Xylanase Enzyme
In this study, potential bacteria-producing xylanase enzymes were identified by examining some morphological and biochemical characteristics as well as the 16S rRNA gene analysis. The boiling method was used to extract bacterial DNA []. The polymerase chain reaction (PCR) technique was utilized to amplify a 1500-bp fragment of the 16S rRNA gene using DNA samples extracted from potential xylanase-producing bacteria by specific primers, as follows: Fd1 (5′-AGAGTT TGATCCTGGCTCAG-3′) and Rd1 (5′-AAGGAGGTGATCCAGCC-3′) (Mankai et al., 2013). The PCR reactions were performed at the initial denaturation at 95 °C for 1 min, followed by 30 cycles at 95 °C for 20 s (denaturation), at 63 °C (hybridization) for 30 s, at 72 °C for 1 min (transcription), and at 72 °C for 5 min (final transcription). The PCR products were sequenced by the Sanger method DNA sequencing (Stab Vida Co. Spain).After sequencing the 16S rRNA genes of the isolated bacteria, the sequencing results were analyzed using the Chromas software and by their comparison with the database bank available in the NCBI (National Center for Biotechnology Information). Moreover, the Blast Online Tool (https://blast.ncbi.nlm.nih.gov/Blast.cgi accessed on 20 August 2022) was employed to analyze the similarities between the amplified genes and the other genes registered in this database. Then, the isolated bacteria were registered at the NCBI. Phylogenetic tree mapping of the 16S rRNA gene sequences of the isolated strains was performed using the MEGA X software, following the edition and alignment of the sequences using the neighbor-joining method. The evolutionary or phylogenetic analysis, along with two bacterial strains isolated from the green alga Ulva flexuosa and eight samples of sequences registered in the NCBI (most similar), were used to study the phylogeny. Methanobacterium formicicum (AY196659.1) was also used to create an outgroup branch when drawing a phylogenetic tree.
2.7. Analysis of the Impact of pH on Xylanase Production
The effect of pH on xylanase production in the culture medium was measured at pH values of 6, 7, and 8 in the potential xylanase-producing bacteria. For this purpose, after 48 h of the growth of selected bacterial strains in a specific culture medium containing leaf mineral salts, the enzyme activity was determined.
2.8. Assessment of the Effect of Temperature on Xylanase Generation
The impact of temperature on xylanase production was measured by incubating the culture medium of potential enzyme-producing bacteria at 25, 30, and 35 °C. For this purpose, after 48 h of the growth of selected bacterial strains in a specific culture medium containing leaf mineral salts, the enzyme activity was evaluated.
2.9. Evaluation of the Effect of Nitrogen and Carbon Source on Xylanase Production
The effect of the nitrogen source on xylanase production was investigated separately using a specific culture medium containing leaf mineral salts with different nitrogen sources, including ammonium sulfate, peptone, and urea. For this purpose, after 48 h of the growth of selected bacterial strains, the enzyme activity was determined. The effect of the carbon source on xylanase production was analyzed separately using a specific culture medium containing leaf mineral salts with different carbon sources, including glucose, sucrose, and xylan. For this purpose, after 48 h of the growth of selected bacterial strains, the enzyme activity was monitored.
3. Results
In this study, fromthe samples collected from the coastal areas, 28 colonies of bacteria from the green alga Ulva flexuosa were isolated on the nutrient agar medium. As shown in Figure 1, the specimens of the green alga Ulva flexuosa were gathered from different tidal regions of the coasts of Hormozgan province, Iran, including the coasts of Bandar Abbas (27 degrees and 18 min North and 56 degrees and 32 min East) and Qeshm Island (26 degrees and 58 min North and 56 degrees and 50 min East).

Figure 1.
The original location of Ulva flexuosa in the Persian Gulf; samples were gathered from Qeshm and Bandar Abbas on the north shore of the Persian Gulf, Hormozgan province, Iran.
In order to isolate xylanase-producing bacteria, a specific culture medium containing xylan was used. Out of the 28 colonies isolated from the algae in the previous stage, 9 colonies were not able to grow in the specific culture medium, implying the lack of xylanase in these bacteria and, therefore, the absence of a carbon source for their growth. The remaining bacterial strains (19 strains) were capable of generating the xylanase enzyme; among them, 10 strains created strong and medium halos, while the others made weak or no halos. Finally, ten strains with the highest ability to create halos in the bacterial culture medium were chosen for further analyses (Figure 2).
Figure 2.
Linear culture colonies (A), single colony selection (B), growth of xylanase-producing bacteria in a specific solid culture medium containing xylan (C), and a clear halo around the colony of xylanase-producing bacteria using Congo red (D).
Among the ten selected bacteria, the HR05 and HR06 strains had the highest xylanase activity (0.16 and 0.13 IU, respectively) and were selected for further experiments and molecular analyses.
The 16S rRNA genes of the two chosen bacterial strains, HR06 and HR05, were sequenced and assessed. The results showed that the nucleotide sequences of HR05 and HR06 strains had the most similarities to Bacillus and Shewanella of the Bacillaceae and Shewanellaceae families, respectively. Moreover, 99% similarity was shown between the two strains HR05 and HR06 and Bacillus subtilis strain TN12 (MF033108.1) andalga Shewanella strain MARS 14 (LN795823.1 sequence was registered in NCBI). The rRNA sequences of Bacillus subtilis strain HR05 and Shewanella algae strain HR06 were registered in NCBI with access numbers MK283758 and MK283759, respectively.
The phylogenetic tree and the evolutionary relationships between the nucleotide sequences of the HR05 and HR06 strains and the eight strains, including Bacillus subtilis strain TN12 (MF033108.1), Bacillus licheniformis strain Dou-6 (KT985636.1), Bacillus tequilensis KRY23 (KT985636.1). Bacillus mojavensis strain WSE-KSU305 (HM753629.1), alga Shewanella strain MARS 14 (LN795823.1), Shewanella algae strain 159418 (MH361602.1), Shewanella haliotis strain DW01 (NR_117770.1), and Shewanella upenei strain VITVAGJ (KP090164.1), are depicted in Figure 3.

Figure 3.
Phylogenetictree of 16S rRNA nucleotide sequences in the examined strains (a 0.05 nucleotide replacement rate per site).
The phylogenetic tree is divided into two main categories; the first category corresponds to the HR06 strain, alga Shewanella strain MARS 14, alga Shewanella strain 159418, Shewanella haliotis strain DW01, and Shewanella upenei strain VITVAGJ, while the second category pertains to the HR05 strain, Bacillus subtilis TN12 strain Dou-6, Bacillus tequilensis strain HYM43, and Bacillus mojavensis strain WSE-KSU305. According to the results, the examined HR05 and HR06 strains had the highest relationshipsbased on the evolutionary pathway—with Bacillus subtilis strain TN12 and alga Shewanella strain 159418, respectively.
The results demonstrated that these two strains had different optimal conditions for enzyme production. The maximum enzyme production in Bacillus subtilis strain HR05 andalga Shewanella strain HR06 was reported to be at a pH value of 6. Although the maximum enzyme production (and/or activity) in Bacillus subtilis strain HR05 was detected at a pH value of 6, the enzyme production rate was decreased at the pH values of 7 and 8. Alga Shewanella strain HR06 had an optimal enzyme production rate at a pH value of 6 (yielding the highest enzyme production), while at a pH value of 7, the enzyme production rate was reduced, and finally, at a pH value of 8, the enzyme production rate decreased significantly. In general, between the isolated bacterial strains, Bacillus subtilis strain HR05 had a wider range of pH tolerability compared withalga Shewanella strain HR06. Therefore, the maximum amount of xylanase production was achieved in acidic conditions compared to neutral and alkaline conditions (Figure 4).

Figure 4.
Optimization of xylanase production in HR05 (▲) and HR06 (■) at different pH values.
The highest enzyme production in Bacillus subtilis strain HR05 was reported to be at 30 °C, whereas the lowest production rate was observed at 40 °C. However, inalga Shewanella strain HR06, the optimum temperature for enzyme production was reported to be 35 °C, while the lowest enzyme production rate was detected at 40 °C (Figure 5).

Figure 5.
Optimization of xylanase production in HR05 (▲) and HR06 (■) at different temperatures.
The highest enzyme production was observed when the two isolated bacteria were grown on the ammonium sulfate medium as a nitrogen source; however, the enzyme production rate began to decrease when they were cultured on a culture medium containing peptone and urea, respectively. The above results indicate that the two different xylanase-producing strains show a similar trend in maximum enzyme production in various nitrogen sources (Figure 6).

Figure 6.
Optimization of enzyme production in HR05 (▲) and HR06 (■) using different nitrogen sources.
The maximum enzyme production in Bacillus subtilis strain HR05 was achieved in a glucose-containing culture medium, whereas the enzyme production rates were reduced when the bacterium was grown on sucrose- and xylan-containing culture media as carbon sources, respectively. However, alga Shewanella strain HR06 showed the highest enzyme production in the culture medium containing sucrose, while such a production rate was diminished in the culture medium containing glucose and xylan (Figure 7).

Figure 7.
Optimization results of enzyme productionin HR05 (▲) and HR06 (■) using different carbon sources.
4. Discussion
The marine environment possesses a rich biodiversity environment in which a broad range of microorganisms with beneficial applications are dispersed in the seas.Depending on the habitat and ecological structure ofthe marine fungi and bacteria, they are capable of generating a variety of enzymes that not only catalyze chemical reactions within cells but also mediate mineralization processes in organic compounds, resulting in the decomposition and cycle of materials in various environments. Enzymes derived from marine microorganisms are of particularimportance as their stability can be markedly higher than their counterparts in animals and plants []. In addition, they can possess unique molecular properties in comparison to their counterparts in terrestrial microorganisms, in terms of tolerability to temperature, pH, pressure, light conditions, and salinity. These characteristics have made them suitable for use in different industries []. Among enzymes derived from marine bacteria, xylanase has attracted much attention due to its ability to be utilized in thebread baking industry (via the improvement in bread texture and the reduction in dough fermentation time), pulp bleaching (through a decrease in environmental pollution and an increase in the brightness of the paper), livestock feed production (with an increment innutritional values as a result of hemicellulose hydrolysis and higher nutrition absorption) []. This investigation was conducted to isolate xylanase-producing bacteria from the symbiotic bacteria associated withgreen alga Ulva flexousa living on the coast of Qeshm Island and Bandar Abbas; they were characterized based on morphological characteristics, gram staining, and molecular identification. The results indicated that the two examined strains, HR05 and HR06, based on the evolutionary pathway, had the highest similarity to Bacillus subtilis strain TN12 and Shewanella algae strain 159418, respectively. In a study conducted by Kumar et al., the production of xylanase from bacterial strains isolated from seawater on the coast of Kovalam was investigated. They isolated 12 bacterial strains from the coastal sediments and prepared a serial dilution (10 times, at 37 °C for 48 h) and cultured the isolated bacteria in a specific culture medium containing xylan as a substrate. Among the isolated bacteria, ten strains showed the highest enzyme production. Isolated strains with high enzyme production wereseparately re-cultured in a xylan-specific culture medium (24 h), and their enzyme activity was measured using the 3,5-dinitrosalicylic acid (DNS) reagent. It should be noted that the results of the enzyme activity of xylanase in the study of Kumar and colleagues were in agreement with our findings [].
The two isolated strains efficiently generated xylanase with an optimal activity at a pH value of 6.0. The crude xylanase-containing specimens exhibited acceptable stability at a pH range between 6.0 and 8.0. Nevertheless, there was more crude enzyme activity isolated from the HR05 strain between the pH values of 8 and 9 in comparison with the HR06 strain, as it retained more than 78% and 43% of its activity, respectively, either due to more enzyme production or enhanced enzyme activity at those pH values. The activity of the crude form of the xylanase enzymes isolated from the HR05 and HR06 strains was optimal when the strains were grown at temperatures of 30 and 35 °C, respectively. With regard to these statements, the optimal temperature and pH values for the production of xylanase using Birchwood xylan have also been reported in β-1,4-xylanase (pH 5.0 and 45 °C) from Phoma sp. MF13 [], β-1,4-xylanase (pH 8 and 40 °C) from Bacillus pumilus GESF1 [], β-1,4-xylanase (pH 8 and 50 °C) from Bacillus arseniciselenatis strain DSM-15340 [], β-1,4-xylanase (pH 5 and 50 °C) from Trichoderma pleuroticola 08ÇK001 [], and β-1,4-xylanase (pH 7 and 40 °C) from Streptomyces olivaceus MSU3 []. In other studies, the optimal temperature and pH values for the production of xylanase using Birchwood xylan have also been reported in XlnA (pH 6.0 and 60 °C) from Streptomyces lividans [], Xys1L (pH 6.3 and 60 °C) from S. halstedii JM8 [], and XynAS27 (pH 6.5 and 60 °C) from Streptomyces sp. S27 [].
In the present research, the impact of nutritional sources on the production rate of xylanase showed that among the examined carbon sources, the sucrose-substituted medium demonstrated the maximal activity, while the xylan-substituted medium exhibited the least enzyme activity. Our findings were in line with the results of earlier studies performed in this regard [,]. Notably, among the examined nitrogen sources, ammonium sulfate had the maximal activity for xylan production, as well as Peptone in second place, while the use of urea as a nitrogen source led to minimum production of xylanase. Consistently with our findings, Maheswari and Chandra also indicated that the maximum production of xylanase isolated from S. cuspidosporus was found when the bacterium was cultured on the ammonium-substitutedfermentation medium as a nitrogen source []. A study carried out by Sanjivkumar et al. showed that among the examined nitrogen sources (beef extract, yeast extract, urea, tryptone, peptone, ammonium sulfate, and sodium nitrate), the use of the yeast extract-substituted medium resulted in the maximum activity of xylanase, while the minimum activity was obtained when the ammonium phosphate-substituted medium was applied in the culture medium [].
5. Conclusions
The present research was conducted on xylanase production from bacterial strains coexisting with Ulva flexuosa found on the coasts of the Persian Gulf in Hormozgan, Iran. We successfully identified two potential bacterial strains, HR05 and HR06, from isolated bacteria, producing the highest amounts of hemicellulase (beta-1,4-xylanase). These two enzymes had the optimal conditions in terms of pH and temperature as well as carbon and nitrogen sources. However, further studies are warranted to support our findings. Further analyses of marine-derived bacteria from the Persian Gulf could provide valuable information about the ecological role and biodiversityof marine bacteria as well as their applicability in biotechnology.
Author Contributions
A.H. conceived and designed the research; A.P. conducted the experiments; A.P. and A.H. analyzed the data; A.P. wrote and A.H. edited the manuscript. All authors have read and agreed to the published version of the manuscript.
Funding
This research received no external funding.
Institutional Review Board Statement
Not applicable.
Informed Consent Statement
Not applicable.
Data Availability Statement
All data were included in the manuscript.
Acknowledgments
The authors express their gratitude to the research council of the University of Hormozgan for financial support during the course of this project.
Conflicts of Interest
The authors declare no conflict of interest.
References
- Homaei, A.A.; Mymandi, A.B.; Sariri, R.; Kamrani, E.; Stevanato, R.; Etezad, S.-M.; Khajeh, K. Purification and characterization of a novel thermostable luciferase from Benthosema pterotum. J. Photochem. Photobiol. B Biol. 2013, 125, 131–136. [Google Scholar] [CrossRef]
- Shojaei, F.; Homaei, A.; Taherizadeh, M.R.; Kamrani, E. Characterization of biosynthesized chitosan nanoparticles from Penaeus vannamei for the immobilization of P. vannamei protease: An eco-friendly nanobiocatalyst. Int. J. Food Prop. 2017, 20 (Suppl. 2), 1413–1423. [Google Scholar]
- Kerrison, P.D.; Stanley, M.S.; Black, K.D.; Hughes, A.D. Assessing the suitability of twelve polymer substrates for the cultivation of macroalgae Laminaria digitata and Saccharina latissima (Laminariales). Algal Res. 2017, 22, 127–134. [Google Scholar] [CrossRef]
- Susilowati, R.; Sabdono, A.; Widowati, I. Isolation and characterization of bacteria associated with brown algae Sargassum spp. from Panjang Island and their antibacterial activities. Procedia Environ. Sci. 2015, 23, 240–246. [Google Scholar] [CrossRef][Green Version]
- Parte, S.; Sirisha, V.; D’Souza, J. Biotechnological applications of marine enzymes from algae, bacteria, fungi, and sponges. In Advances in Food and Nutrition Research; Elsevier: Amsterdam, The Netherlands, 2017; Volume 80, pp. 75–106. [Google Scholar]
- Qeshmi, F.I.; Homaei, A.; Fernandes, P.; Hemmati, R.; Dijkstra, B.W.; Khajeh, K. Xylanases from marine microorganisms: A brief overview on scope, sources, features and potential applications. Biochim. Biophys. Acta (BBA)-Proteins Proteomics 2020, 1868, 140312. [Google Scholar] [CrossRef]
- Fleurence, J. The enzymatic degradation of algal cell walls: A useful approach for improving protein accessibility? J. Appl. Phycol. 1999, 11, 313–314. [Google Scholar] [CrossRef]
- Hardouin, K.; Bedoux, G.; Burlot, A.-S.; Donnay-Moreno, C.; Bergé, J.-P.; Nyvall-Collén, P.; Bourgougnon, N. Enzyme-assisted extraction (EAE) for the production of antiviral and antioxidant extracts from the green seaweed Ulva armoricana (Ulvales, Ulvophyceae). Algal Res. 2016, 16, 233–239. [Google Scholar] [CrossRef]
- Thomas, L.; Joseph, A.; Singhania, R.R.; Patel, A.; Pandey, A. Industrial enzymes: Xylanases. In Current Developments in Biotechnology and Bioengineering; Elsevier: Amsterdam, The Netherlands, 2017; pp. 127–148. [Google Scholar]
- Hung, K.-S.; Liu, S.-M.; Tzou, W.-S.; Lin, F.-P.; Pan, C.-L.; Fang, T.-Y.; Sun, K.-H.; Tang, S.-J. Characterization of a novel GH10 thermostable, halophilic xylanase from the marine bacterium Thermoanaerobacterium saccharolyticum NTOU1. Process Biochem. 2011, 46, 1257–1263. [Google Scholar] [CrossRef]
- Sanjivkumar, M.; Silambarasan, T.; Palavesam, A.; Immanuel, G. Biosynthesis, purification and characterization of β-1, 4-xylanase from a novel mangrove associated actinobacterium Streptomyces olivaceus (MSU3) and its applications. Protein Expr. Purif. 2017, 130, 1–12. [Google Scholar] [CrossRef] [PubMed]
- Dos Santos, J.P.; da Rosa Zavareze, E.; Dias, A.R.G.; Vanier, N.L. Immobilization of xylanase and xylanase–β-cyclodextrin complex in polyvinyl alcohol via electrospinning improves enzyme activity at a wide pH and temperature range. Int. J. Biol. Macromol. 2018, 118, 1676–1684. [Google Scholar] [CrossRef]
- Chen, Q.; Li, M.; Wang, X. Enzymology properties of two different xylanases and their impacts on growth performance and intestinal microflora of weaned piglets. Anim. Nutr. 2016, 2, 18–23. [Google Scholar] [CrossRef] [PubMed]
- Ranjbaran, F.; Homaei, A.; Shayesteh, F. Isolation and Identification of Protease Producing Bacteria Kocuria sp. Strain HR12coexistence of Avicennia Marina from West Coastal Area of Qeshm Island (KonarSiah). Biomacromol. J. 2020, 6, 163–172. [Google Scholar]
- Beygmoradi, A.; Homaei, A. Marine microbes as a valuable resource for brand new industrial biocatalysts. Biocatal. Agric. Biotechnol. 2017, 11, 131–152. [Google Scholar] [CrossRef]
- Sharifian, S.; Homaei, A.; Kim, S.-K.; Satari, M. Production of newfound alkaline phosphatases from marine organisms with potential functions and industrial applications. Process Biochem. 2018, 64, 103–115. [Google Scholar] [CrossRef]
- Kumar, P.S.; Yaashikaa, P.; Saravanan, A. Isolation, characterization and purification of xylanase producing bacteria from sea sediment. Biocatal. Agric. Biotechnol. 2018, 13, 299–303. [Google Scholar] [CrossRef]
- Wu, J.; Qiu, C.; Ren, Y.; Yan, R.; Ye, X.; Wang, G. Novel salt-tolerant xylanase from a mangrove-isolated fungus Phoma sp. MF13 and its application in Chinese steamed bread. ACS Omega 2018, 3, 3708–3716. [Google Scholar] [CrossRef]
- Menon, G.; Mody, K.; Keshri, J.; Jha, B. Isolation, purification, and characterization of haloalkaline xylanase from a marine Bacillus pumilus strain, GESF-1. Biotechnol. Bioprocess Eng. 2010, 15, 998–1005. [Google Scholar] [CrossRef]
- Parab, P.; Khandeparker, R.; Amberkar, U.; Khodse, V. Enzymatic saccharification of seaweeds into fermentable sugars by xylanase from marine Bacillus sp. strain BT21. 3 Biotech 2017, 7, 296. [Google Scholar] [CrossRef]
- Korkmaz, M.N.; Ozdemir, S.C.; Uzel, A. Xylanase production from marine derived Trichoderma pleuroticola 08ÇK001 strain isolated from Mediterranean coastal sediments. J. Basic Microbiol. 2017, 57, 839–851. [Google Scholar] [CrossRef]
- Morosoli, R.; Bertrand, J.-L.; Mondou, F.; Shareck, F.O.; Kluepfel, D. Purification and properties of a xylanase from Streptomyces lividans. Biochem. J. 1986, 239, 587–592. [Google Scholar] [CrossRef]
- Ruiz-Arribas, A.; Sanchez, P.; Calvete, J.J.; Raida, M.; Fernández-Abalos, J.M.; Santamaría, R.I. Analysis of xysA, a gene from Streptomyces halstedii JM8 that encodes a 45-kilodalton modular xylanase, Xys1. Appl. Environ. Microbiol. 1997, 63, 2983–2988. [Google Scholar] [CrossRef] [PubMed]
- Li, N.; Shi, P.; Yang, P.; Wang, Y.; Luo, H.; Bai, Y.; Zhou, Z.; Yao, B. A xylanase with high pH stability from Streptomyces sp. S27 and its carbohydrate-binding module with/without linker-region-truncated versions. Appl. Microbiol. Biotechnol. 2009, 83, 99–107. [Google Scholar] [CrossRef] [PubMed]
- Thomas, L.; Sindhu, R.; Pandey, A. Identification and characterization of a highly alkaline and thermotolerant novel xylanase from Streptomyces sp. Biologia 2013, 68, 1022–1027. [Google Scholar] [CrossRef]
- Maheswari, M.U.; Chandra, T. Production and potential applications of a xylanase from a new strain of Streptomyces cuspidosporus. World J. Microbiol. Biotechnol. 2000, 16, 257–263. [Google Scholar] [CrossRef]
Publisher’s Note: MDPI stays neutral with regard to jurisdictional claims in published maps and institutional affiliations. |
© 2022 by the authors. Licensee MDPI, Basel, Switzerland. This article is an open access article distributed under the terms and conditions of the Creative Commons Attribution (CC BY) license (https://creativecommons.org/licenses/by/4.0/).